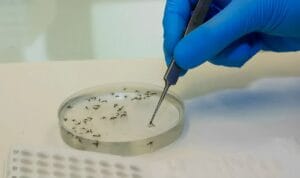

Febre Oropouche: Tudo que Você Precisa Saber
A febre Oropouche é uma doença viral que tem ganhado atenção no Brasil e nas…
Como Regular a Pressão Alta Naturalmente
A pressão alta, ou hipertensão arterial, é uma condição silenciosa que afeta cerca de 38…
Como o Sedentarismo Impacta na Sua Saúde e Estratégias para Combatê-lo
O sedentarismo é um dos maiores desafios de saúde pública do século XXI, afetando milhões…
O Que é SOP: Sintomas, Tratamento e Dieta Ideal
A Síndrome dos Ovários Policísticos (SOP), ou PCOS em inglês, é uma das condições hormonais…
O Que é Linfedema: Causas, Sintomas e Tratamento
O linfedema é caracterizado pelo acúmulo anormal de líquido linfático nos tecidos do corpo, ele…
Como Saber Se Tenho Ansiedade?
A ansiedade é uma realidade que atravessa a vida de milhões de pessoas ao redor…
Novo Medicamento Oral para Obesidade Mostra Eficácia Superior à Semaglutida
Recentemente, a farmacêutica Novo Nordisk anunciou resultados impressionantes de um novo medicamento oral chamado Amycretin.…
Como Aliviar Dor de Cabeça Naturalmente
Dor de cabeça é um problema que quase todo mundo já enfrentou alguma vez na…
Envelhecimento da Pele: 5 Hábitos que Aceleram e Como Reverter
O envelhecimento da pele é um processo natural, mas diversos fatores externos e hábitos de…
Rinite Alérgica: Sintomas, Tratamentos e Como Evitar Crises
A rinite alérgica é uma inflamação da mucosa nasal desencadeada pela exposição a alérgenos. Quando…